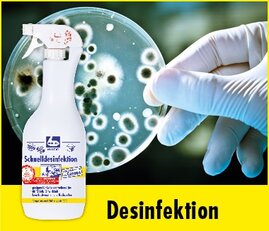
Dr. Becher Desinfectie

Categorieën
-
Tork
add
- Tork Handoek Dispensers
- Tork Toiletpapier Dispensers
- Tork Poetsrol Dispensers
- Tork Zeep Dispensers
- Tork Luchtverfrisser Dispensers
- Tork Afvalbakken
- Tork Divers
- Tork Servetdispensers
- Tork Toiletpapier
- Tork Handdoekjes
- Tork Handdoekrollen
- Tork Poetsrollen
- Tork Handzeep/Verzorging
- Tork Handdesinfectie
- Tork Luchtverfrissers
- Tork Afvalzakken
- Tork Servetten/Servetdispensers
- Tork Bestekzakjes
- Tork Onderzetters
- Tork Placemats
- Tork Tafelrol/Loper/Napperons
- Tork Facial Tissues
- Tork Waslappen
- Tork Werkdoeken
- Ga naar Tork
- BulkySoft add
- Satino by Wepa add
- Elive Products add
-
Hagleitner
add
- Hagleitner Toiletpapier
- Hagleitner Handoekrollen
- Hagleitner Xibu Handdoekdispensers
- Hagleitner Xibu Toiletpapier Dispensers
- Hagleitner Xibu Zeepdispensers
- Hagleitner Xibu Luchtverfrisser Dispensers
- Hagleitner Batterijen/Accessoires
- Hagleitner Bad/toilet Overige
- Hagleitner Sanitair Hygiëne
- Ga naar Hagleitner
- Mavro add
- Dr. Becher remove
- Dipp add
-
SC Johnson Professional
add
- SC Johnson Huidbescherming
- SC Johnson Schuimzeep
- SC Johnson Huidreiniging Industrie - Licht
- SC Johnson Huidreiniging Industrie - Zwaar- Ultra
- SC Johnson Handdesinfectie
- SC Johnson Hygiënische Reiniger
- SC Johnson Huidverzorging
- SC Johnson Swarfega/Janitol
- SC Johnson Dispensers
- Ga naar SC Johnson Professional
- Frosch add
- Zep add
- Syr add
- Wecoline add
- Greenspeed add
- Vileda add
-
FBK (HACCP)
add
- FBK Vegers/Borstels/Schrobbers
- FBK Trekkers/Vervangcassettes
- FBK Stelen
- FBK Handborstels/Handschep/Schop/Lobbypan
- FBK Flessen/Tank/Buizenborstels
- FBK Spatels + Schrapers
- FBK Padhouders + Schuurpads
- FBK Condensvanger + Toebehoren
- FBK Emmer/Deksel
- FBK Metaal Detecteerbaar
- FBK Ophangrail & Toebehoren
- FBK Resin Set
- FBK Waterdoorlatend
- Ga naar FBK (HACCP)
- Orange Brush add
-
Vikan (HACCP)
add
- Vikan Bezems, Schrobbers en Borstels
- Vikan Handvegers en Borstels
- Vikan Vloertrekkers
- Vikan Stelen
- Vikan Stoffer en Blik
- Vikan Emmers
- Vikan Ophangsystemen
- Vikan HyGo Werkwagen
- Vikan Schrapers
- Vikan Schep
- Vikan Schoppen, Vork en Hark
- Vikan Speciale Gereedschappen
- Vikan Handpads en Houders
- Vikan Waterdoorlatende stelen
- Vikan Waterdoorlatende Borstels
- Vikan Waterpistolen en Slangen
- Vikan Schuimende uitrusting
- Vikan Koppelingen
- Ga naar Vikan (HACCP)
-
Vikan - Transport
add
- Vikan Transport Waterdoorlatende Borstels
- Vikan Transport Stelen, Waterdoorlatende Stelen en Telescoopstelen
- Vikan Transport Handvegers en Borstels en Blik
- Vikan Transport Trekkers en Schop
- Vikan Transport Bezems en Vloertrekker
- Vikan Transport Slangenset, Wandhouder, Spuitpistool en Koppelingen
- Ga naar Vikan - Transport
- Moerman add
- Unger add
-
iVo Benelux
add
- iVo Giotto Mop/Werkwagens
- iVo Stofzuigers + Accessoires
- iVo Artist Schrob/Zuigmachines
- iVo Power Pro XL Schrobmachine + Accessoires
- iVo Mini E-Pulire Schrobmachine + Accessoires
- iVo Schrob/Zuigmachines + Accessoires
- iVo Orbital machine + Accessoires
- iVo schrobzuigmachine opzit + Accessoires
- iVo Activa Edge Oscillerende/ Schrobmachine + Accessoires
- iVo Eenschijfsmachines/Orbital + Accessoires
- iVo Floorwash + Accessoires
- iVo SprayMax + Accessoires
- iVo Foam Sprayers / Sprayers
- iVo Veegmachines + Accessoires
- iVo Blue line Waterzuigers + Accessoires
- iVo Clean-Vac Fijnstof Stofzuiger + Accessoires
- iVo Clean-Tapijt Extractor + Accessoires
- iVo Aspirik Stedelijke stofzuiger
- iVo Stoomreinigers
- iVo Orbipro + Accessoires
- iVo Toppads
- iVo Banana Cone
- iVo Doseersystemen / Pompen / Div Toebehoren
- iVo Sprayers
- iVo Microvezeldoeken
- iVo Power Brush XL + Accessoires
- Ga naar iVo Benelux
- DIBO add
- Viper add
- Ghibli add
- Numatic add
- Bolsius Kaarsen add
- Dimensio add
- Herock Workwear add
Filter
Toon alle resultaten
- Onze merken
- Dr. Becher
Dr. Becher
Filter
Product toegevoegd aan jouw offerte. Ga naar de offertepagina om jouw offerte aan te vragen. Wij nemen dan zo spoedig mogelijk contact met je op.
Bezig met laden...

Becher Galakor F8 reiniger voor commerciële vaatwassers 12 kg
Artikelnummer: 1890130
€ 41,29
Prijs per stuk

Becher Galakor F9 reiniger voor commerciële vaatwassers 12 kg
Artikelnummer: 1775130
€ 38,64
Prijs per stuk

Becher Galakor P7 poederreiniger voor commerciële vaatwassers 10kg
Artikelnummer: 1779130
€ 39,25
Prijs per stuk

Becher Galakor T6 reinigerstabletten voor commerciële vaatwassers 65 st.
Artikelnummer: 1776130
€ 41,35
Prijs per stuk

Becher Zeefinzetstukken voor urinoirs 4 stuks
Artikelnummer: 1570130
€ 20,46
Prijs per set van 4 stuks
Er zijn %s resultaten. Scroll naar boven.

Bel voor persoonlijk advies.
Neem direct contact op:
Kantoor: +31 (0) 30 30 410 57